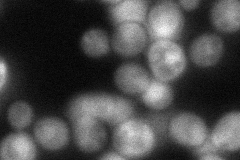
YOR108W
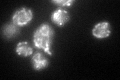
YOR108W

View description
Alpha-isopropylmalate synthase II (2-isopropylmalate synthase), catalyzes the first step in the leucine biosynthesis pathway; the minor isozyme, responsible for the residual alpha-IPMS activity detected in a leu4 null mutant
Localization:
Intensity:
Fold change:
Significance:
-
C’ GFP library in SD

mitochondria69.97 -
N' NOP1pr-GFP in SD

mitochondria144.381 -
N' TEF2pr-mCherry in SD

mitochondria236.604 -
N' NATIVEpr-GFP in SD
cytosol,nucleus56.8069 -
N' TEF2pr-VC and Cyto-VN in SD

#N/A0 -
C’ GFP library in SD+DTT
mitochondria47.080.67No -
C’ GFP library in SD+H2O2

punctateN/AN/ANo -
C’ GFP library in Starvation Media

punctateN/AN/AYes -
C’ GFP library on the background of Pup2-DaMP

mitochondria -
C’ GFP library on the background of CCT mutant

mitochondria90.11551.28779No
